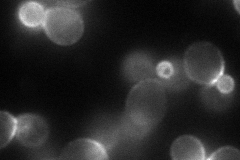
YDR251W
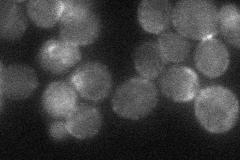
YDR251W

View description
Essential protein of unknown function; exhibits variable expression during colony morphogenesis; overexpression permits survival without protein phosphatase 2A, inhibits growth, and induces a filamentous phenotype
Localization:
Intensity:
Fold change:
Significance:
-
C’ GFP library in SD

below threshold17.32 -
N' NOP1pr-GFP in SD
cell periphery71.1722 -
N' TEF2pr-mCherry in SD

cell periphery89.9971 -
N' NATIVEpr-GFP in SD
bud neck32.0028 -
N' TEF2pr-VC and Cyto-VN in SD

bud41.1711 -
C’ GFP library in SD+DTT

cytosol21.251.22No -
C’ GFP library in SD+H2O2

cytosol16.830.97No -
C’ GFP library in Starvation Media

cytosol18.111.04No -
C’ GFP library on the background of Pup2-DaMP

N/A -
C’ GFP library on the background of CCT mutant

N/A0N/AYes
